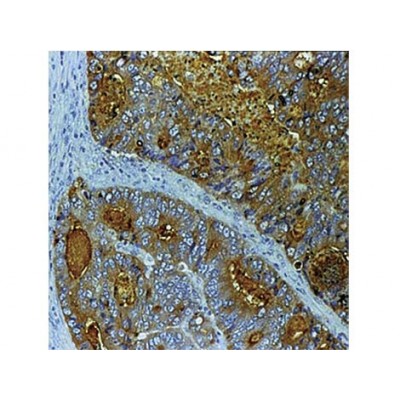
CEA , Col-1 , IgG2a - 0.5ml

CEA , Col-1 , IgG2a - 0.5ml
Monoclonal Mouse Antibody to Human
Carcinoembryonic Antigen (CEA)
F, P/E
Catalog No.: Mob 008 Concentrated 1ml
Mob 008-05 Concentrated 0.5ml
PDM 005 Prediluted 6ml
Immunogen: BALB/C mice were injected with extract of colon carcinoma cells.
Clone: COL-1
Isotype: IgG2a, kappa
Positive Control: Colon Carcinoma
Cellular Localization: Cytoplasmic and lumenal membrane
Specificity: This antibody is a member of a family of complex antigens, which also includes non-specific cross-reacting antigens (NCA). This antibody stains specific regions of CEA. It reacts with colorectal adenocarcinomas but does not show any staining with polymorphonuclear neutrophils and erythrocytes.
F=Frozen P=Formalin Fixed Paraffin Embedded H=Heat Induced Pretreatment E=Enzyme Pretreatment
For more information please visit the DBS website at dbiosys.com
Additional Information
|
SKU |
PAA-MOB 008-05 |
|
Pack of |
1 |
|
Color |
N/A |
|
Hazard |
N/A |
|
Storage Type |
N/A |
|
Construction |
N/A |
- Product: PAA-MOB 008-05
- SKU:
- Availability: Pre-Order
Tags: CEA, Col-1, IgG2a - 0.5ml